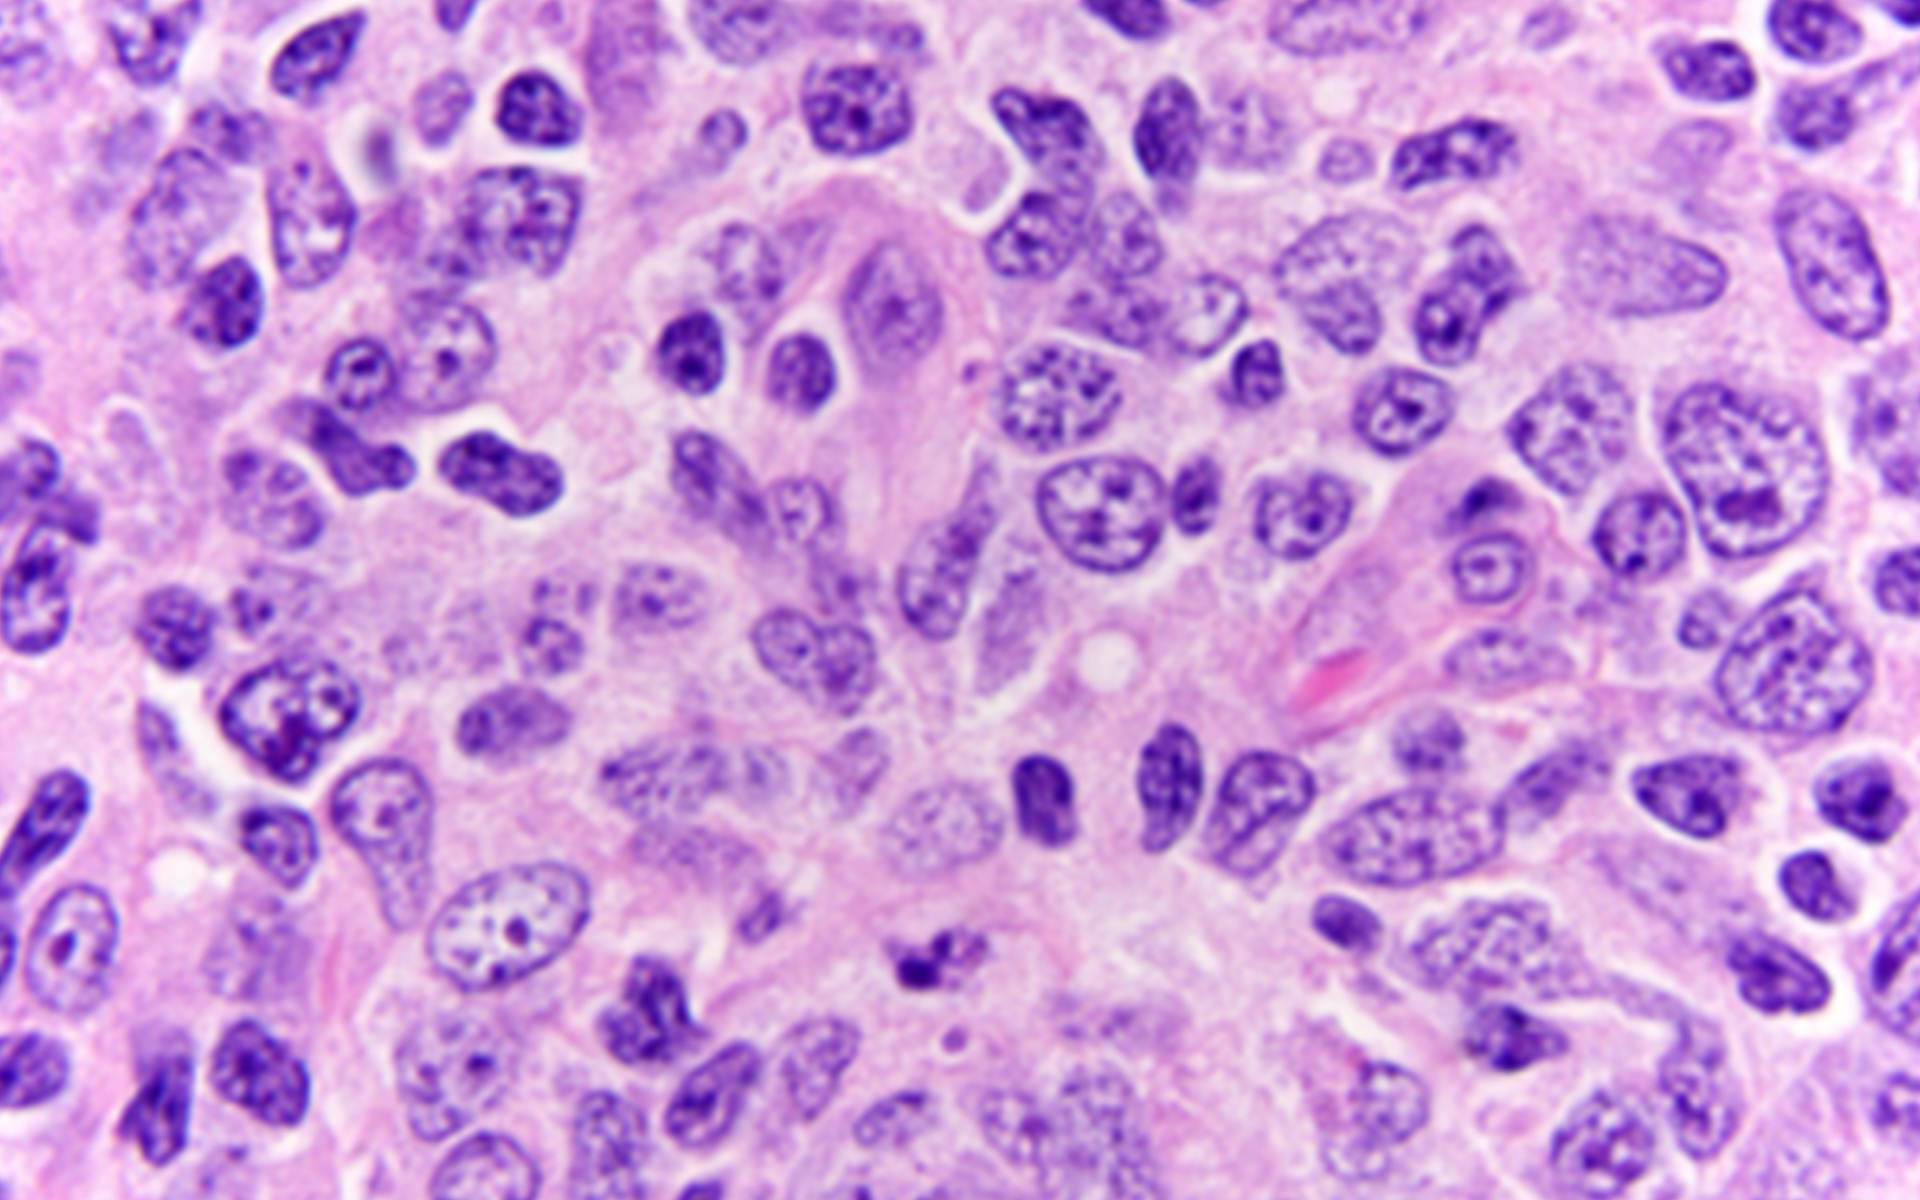
Specifie an alternate text for an image

-
 LymphomasRead the stories of ASCP Patient Champions Brian and Nuan and learn about
LymphomasRead the stories of ASCP Patient Champions Brian and Nuan and learn about
the role of laboratory testing in the diagnosis and treatment of lymphomas.
Non-Hodgkin lymphoma (NHL) is the most common type of lymphoma, and starts in the white blood cells that are part of the body’s immune system. It can be further diagnosed in to different subtypes, of which large B-cell and follicular lymphoma are the most common. It is distinguished from Hodgkin Lymphomas for treatment purposes.

Large cell non-Hodgkin lymphoma is shown with atypical cells.
Large B-cell lymphoma is a type of non-Hodgkin lymphoma. It is an aggressive cancer that can develop in lymph nodes, areas outside of the lymph nodes (such as testes, thyroid, breast, bone) or any organ of the body. It is possible to cure large B-cell lymphoma.
Image features a typical image of large b-cell lymphoma, which is more aggressive, is shown with variation in size, shape, and coloration of the cells including very large cells.
Brian was building up a website design and computer repair company while also acting as the primary caregiver for his young daughter, and his stress levels were on the rise. At the same time, he could tell something wasn’t right with his health, but he couldn’t seem to get any answers from his doctors. But when doctors found a large mass in his chest via CT scan, he finally got the answers—though not the one he was looking for.
Brian was diagnosed with large B-cell lymphoma, a rare subtype of cancer. It is composed of abnormal b cells, which are a type of white blood cells that produce antibodies. The cancer is aggressive, and Brian was diagnosed at stage 3, and the cancer had spread to some lymph nodes but thankfully hadn’t spread to any other organs.
Having worked for a couple of years as a processor in a laboratory environment, Brian was roughly acquainted with some of the testing he underwent, and had a good understanding of workflows and time frames for the various cultures and biopsies he had to have. Having undergone chemotherapy, and 40 total rounds of radiation, Brian has added to his knowledge of the laboratory. “I have learned that my doctors tend to disregard abnormal test results, especially if there are no symptoms and the test doesn’t directly diagnose something,” he says. “If the numbers are slightly off, I usually have to request further testing.”

Brian has been in remission since 2016, and gets a CT scan every six months as part of his follow-up care. His wife and daughter, he says, have been essential to his recovery, along with his doctors, friends and family. “Ultimately, trust your doctors and their treatments,” he says, “but do not be afraid to question them or ask for further testing if something health-related is not right.”
In 2015, Nuan was diagnosed with Type B, stage 2 Non-Hodgkin lymphoma. She started treatment immediately and completed it in May of 2016. But by the end of that same year, the lymphoma had returned, in the same spot, and the same type. Thankfully, it hadn’t spread, and Nuan once again started chemotherapy and radiation treatment, which she completed in August 2017.
Prior to his diagnosis, Nuan had the same understanding of the laboratory that most people do—cholesterol, HDL, LDL, and triglyceride numbers that are checked from time to time. But after being diagnosed with Non-Hodgkin lymphoma, she better understands that she can use the lab to monitor her diet and health. Nuan encourages people to learn about the lab and ask questions about their lab results, and what the doctors and nurses are looking for so patients can monitor it themselves as well, and compare it to past lab results.
Before being diagnosed, Nuan says she didn’t think much about her health. “I always heard about other people having cancer,” she says. “I never thought it could have happened to me.” But since his diagnosis, she’s become more health conscious, changed her diet, and exercises and meditates regularly to “keep my body and mind together.” Being a regular mediator helped Nuan during her diagnosis and treatment, she says. She had no fears or worries, just focused on what she needed to do to get cured. And she believes her health is much better now than it was before her cancer diagnosis.

“I feel that I am blessed,” she says. “I count my blessings every day. I still continue doing good karma so I will be happy and feel content in what I have with gratitude.”